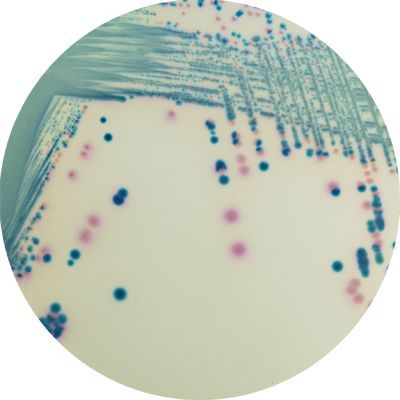
CHROMagar™ mSuperCARBA™ - 25 L

ERTS2
For overnight detection of Gram-negative bacteria producing Extended Spectrum Beta-Lactamase
Package size: 5000 ml
DKK 3.000,00
DKK 13.125,00
Not in stock, delivery 1-2 weeks
Chromogenic medium for detecton and isolaton of Carbapenemase-producing Enterobacteriaceae (CPE).
The product is composed of a powder base (B) and 2 supplements (S1 + S2).
MEDIUM PERFORMANCE:
1. Highly sensitive: Most Carbapenemases (including OXA-48 and OXA-48 like) detected after overnight incubation.
2. Impressive limit of detection of 10 CFU/mL
3. Highly selective and specific: Not only beta-lactam susceptible bacteria are inhibited, but also most of the ESBL and AmpC hyperproducers are inhibited, rendering the tool very specific for carbapenemase-producing bacteria.
TYPICAL APPEARANCE OF MICROORGANISMS:
CPE E. coli → dark pink to reddish
CPE Coliforms → metallic blue
CPO Pseudomonas → translucent, +/- natural pigmentation cream to green
CPO Acinetobacter → Cream
Other Gram negative CPO → colourless, natural pigmentation
Non-CPO E. coli/ Coliforms → inhibited
Other Gram (-) non-CPO → inhibited
CRE Epidemiologic Issues
CDC: «Carbapenem-resistant Enterobacteriaceae (CRE) are usually resistant to all β-lactam agents as well as most other classes of antimicrobial agents. The treatment options for patients infected with CRE are very limited. Healthcare-associated outbreaks of CRE have been reported. Patients colonized with CRE are thought to be a source of transmission in the healthcare setting. Identifying patients who are colonized with CRE and placing these patients in isolation precautions may be an important step in preventing transmission».
CHROMagar launched in 2007 the first chromogenic medium for the detection of carbapenem-resistant bacteria, particularly targeting KPC-enzymes. Since then, many other carbapenemases have been spreading around the world and therefore there was a need to address today the difficult detection of low level carbapemases.
Alain Rambach and Patrice Nordmann have joined their efforts to develop a highly sensitive chromogenic medium, CHROMagar™ mSuperCARBA™, the new generation of chromogenic media that reaches unprecedented performances: detection of a large variety of carbapenemases KPC, NDM, VIM, IMP, OXA…with an impressive limit of detection (10 CFU/mL) even for weakly expressed carbapenemases like OXA-48, while maintaining a high level of selectivity.
Also available in 5000 ml (SC172).